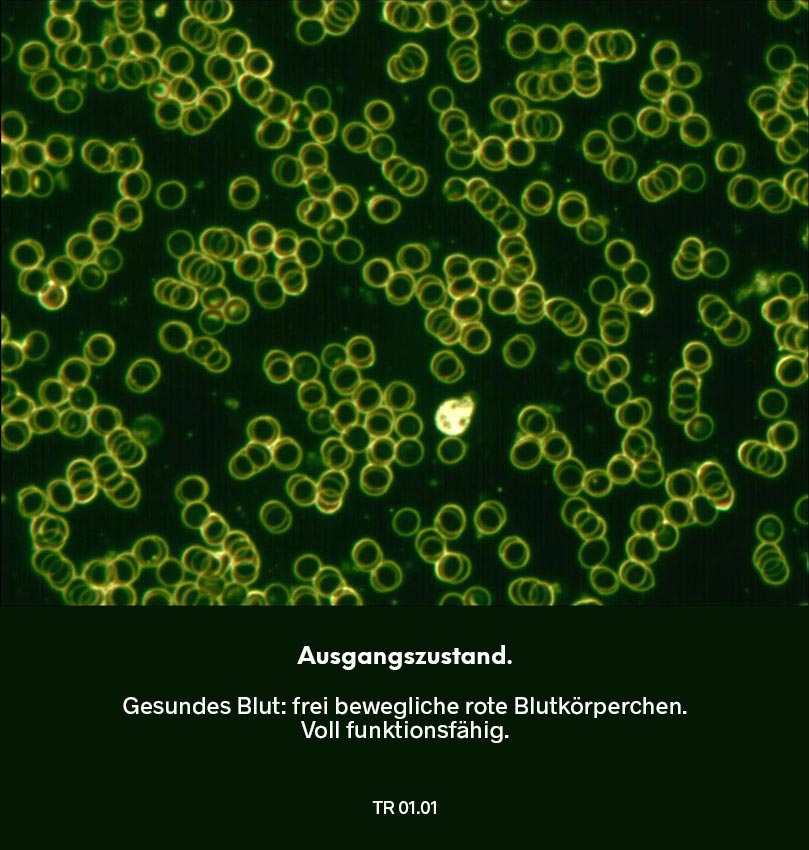
Dunkelfeldmikroskopie Testreihe 01: Ausgangszustand – Blutprobe mit frei beweglichen roten Blutkörperchen ohne Verklumpungen.
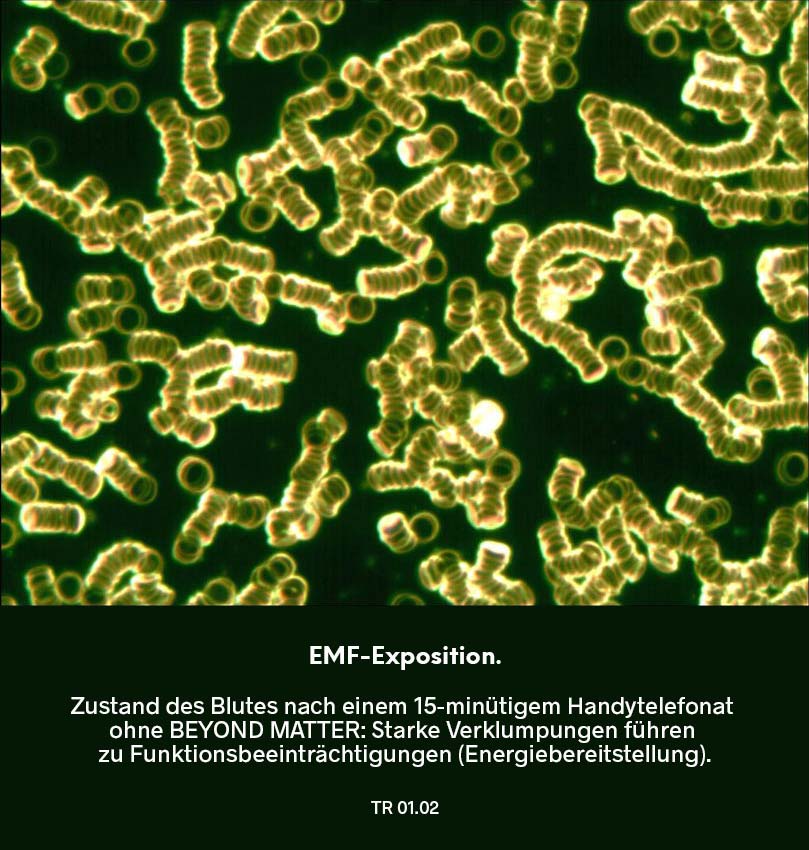
Dunkelfeldmikroskopie Testreihe 01: Blutprobe nach EMF-Exposition – Dauer 15 Minuten: deutliche Verklumpungen der roten Blutkörperchen.
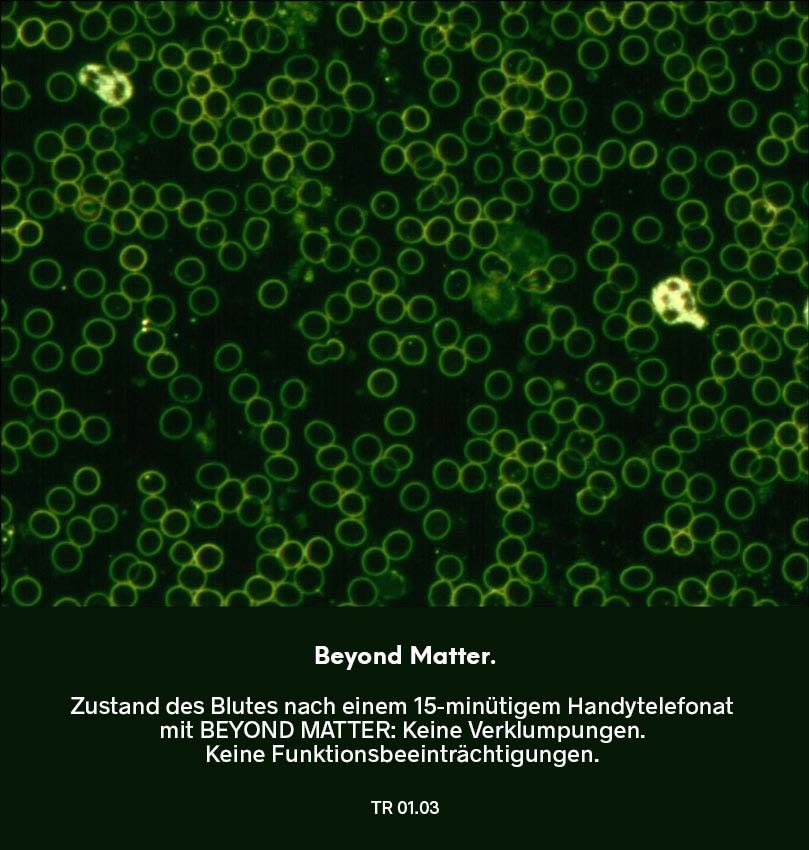
Dunkelfeldmikroskopie Testreihe 01: Blutprobe nach Nutzung von Beyond Matter – Dauer 15 Minuten: frei bewegliche rote Blutkörperchen ohne Verklumpungen und verbesserte Struktur.
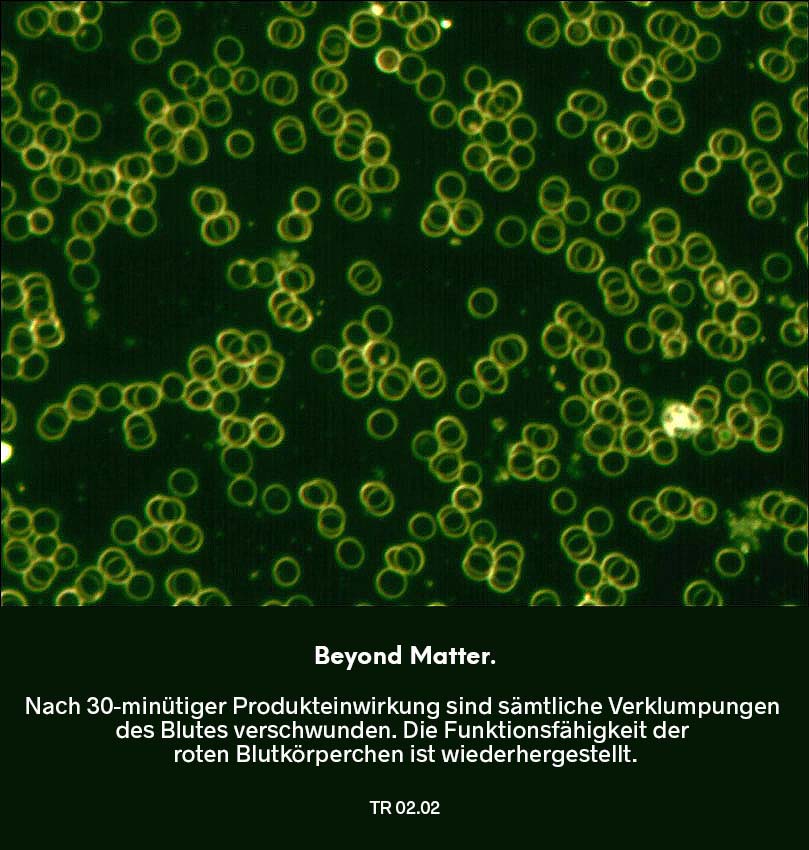
Dunkelfeldmikroskopie Testreihe 02: Blutprobe nach Nutzung von Beyond Matter – Dauer 30 Minuten: frei bewegliche rote Blutkörperchen ohne Verklumpungen und verbesserte Struktur.
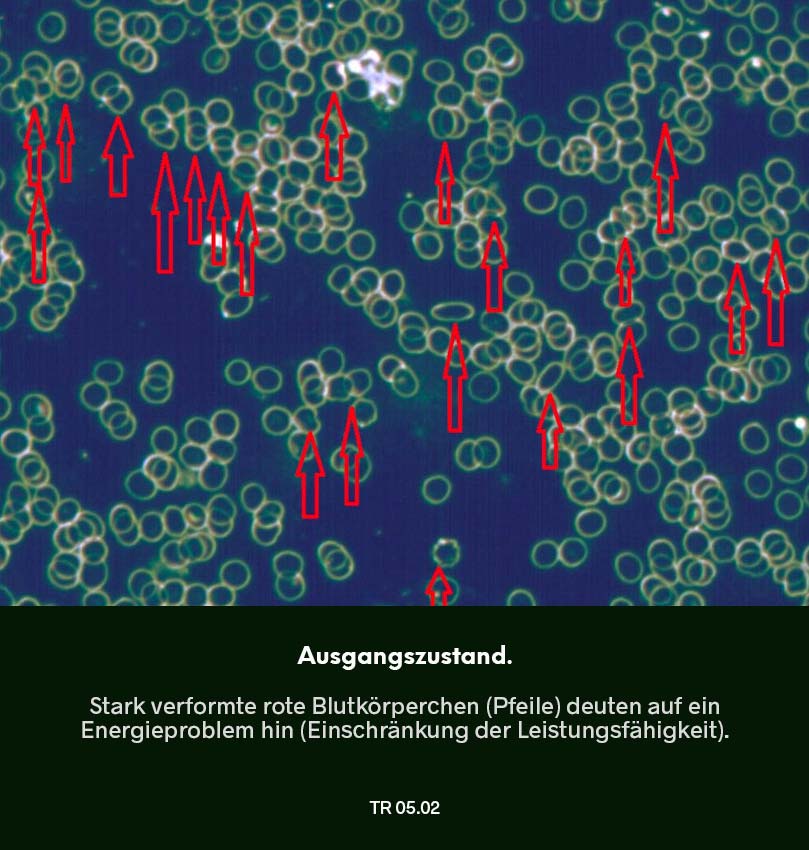
Dunkelfeldmikroskopie Testreihe 04:  Ausgangszustand – Blutprobe mit starken Verklumpungen und deutlich eingeschränkter Beweglichkeit der roten Blutkörperchen (Hinweis auf Energieproblem).
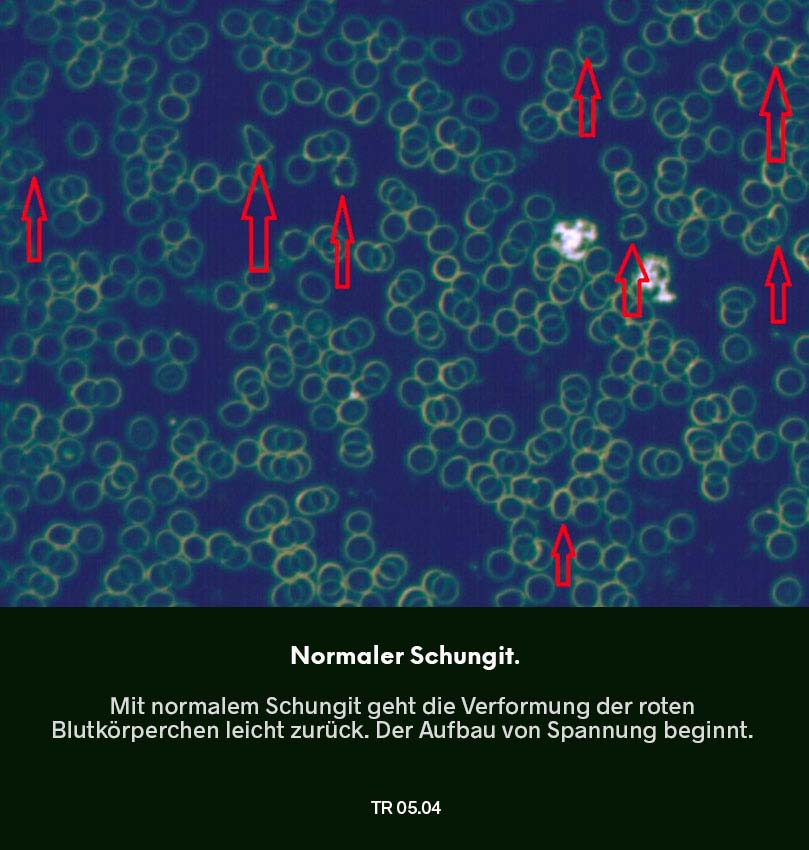
Dunkelfeldmikroskopie Testreihe 04: Blutprobe nach Nutzung von normalem Schungit – Verklumpungen der roten Blutkörperchen gehen leicht reduziert, markierter Bereich im Bild.

Beyond Matter: Schutzschild für dein Blut.
Mit der Dunkelfeldmikroskopie (DFM) lässt sich der Gesundheitszustand des Blutes analysieren. DFM gibt Aufschluss über Vitalität und Wohlbefinden – Schlüsselfaktoren, die durch Elektrosmog beeinträchtigt werden.
Insbesondere kann eine korrekt ausgeführte DFM Hinweise über die elektromagnetische Integrität der roten Blutkörperchen geben, deren eisenhaltiges Hämoglobin für einen effizienten Sauerstofftransport essenziell ist.
Die durchgeführten Studien belegen, dass Elektrosmog zuvor gesundes Blut stark verklumpen lässt, was die Sauerstoffversorgung beeinträchtigt und ein Gefühl von Erschöpfung fördert.
Dunkelfeld
- Analyseverfahren
- Kapillarblut
- Expertise
Die Dunkelfeldmikroskopie (DFM) ist ein alternativmedizinisches Diagnoseverfahren. Dabei wird Blut unter einem Dunkelfeldmikroskop untersucht.
Aufgrund des speziellen Aufnahmeverfahrens – das Präparat wird seitlich stark belichtet, so dass gewöhnliche Lichtstrahlen nicht in das Objektiv des Mikroskops eindringen – heben sich die zu beobachtenden Zellen hell vor einem dunklen Bildhintergrund ab. Dadurch wird alles, was im Blut enthalten ist, optisch sichtbar gemacht.
Um eine Untersuchung des Bluts mittels DFM durchzuführen, wird dem Patienten ein kleiner Tropfen Kapillarblut entnommen.
Das Kapillarblut ist Blut aus den Endstrombahnabschnitten des Gefäßsystems, also den Haar- bzw. Kapillargefäßen des Körpers.
Im Blut der Kapillaren sind wichtige Informationen über die Stoffwechselprozesse im Körper enthalten, daher wird es nicht für Dunkelfeldmikroskopie, sondern für verschiedene Laboruntersuchungen entnommen.
Die Blutentnahme (Punktion) erfolgt an einem gut durchbluteten Körperteil, wie beispielsweise der sog. „Fingerbeere“, dem handflächenseitigem Teil der Fingerkuppe.
Im Dunkelfeldmikroskop kann der Blutstropfen um den Faktor 1000 vergrößert werden. Das Blut bleibt dabei völlig unbehandelt; es wird also exakt so bewertet, wie es im Körper zirkuliert.
Die Dunkelfeldmikroskopie ist ein sensibles Verfahren, das den Zustand des Blutes visualisiert und Aufschluss über Vitalität und Wohlbefinden gibt. Da Elektrosmog diese Aspekte beeinflusst, ist eine korrekte Durchführung der DFM entscheidend.
Kurzum: Um die Wirksamkeit von Schutzmaßnahmen gegen Elektrosmog mittels DFM zu belegen, ist Expertise unerlässlich. Fehlinterpretationen durch ungenaue Probenentnahme oder Fokuswahl – wie das Vergleichen von Rand- und Zentralbereichen des Blutstropfens – verfälschen die Ergebnisse. Solche manipulierten Bilder taugen nicht als Beleg.
Eine seriöse DFM-Analyse konzentriert sich auf den mittleren Bereich des Blutstropfens, um ein valides Bild zu erhalten. Daher ist die Wahl eines erfahrenen und unabhängigen Experten entscheidend.
DFM belegt: Beyond Matter schützt dein Blut vor den Auswirkungen von Elektrosmog.
Elektrosmog lässt dein Blut verklumpen.
Der Zustand deines Blutes zeigt, wie es dir gesundheitlich geht. Und Untersuchungen im Dunkelfeld zeigen: Elektrosmog stresst dein Blut.
Vor der Exposition durch ein Handytelefonat zeigt das Blutbild einen gesunden Zustand; sprich: keine Verklumpungen. Nach 10 bis 12 Minuten Exposition ohne Schutz treten starke Verklumpungen auf.
Dieselbe Expositionszeit mit Schutz durch Chip Ava schützt dein Blut: Verklumpungen treten nicht auf! Besser noch: In einigen Fällen kommt es zu einer Verbesserung des Ausgangszustands!
01
Ausgangszustand.
Das Blut vor Beginn der Testung, d.h. vor EMF-Exposition mittels Handy: guter, gesunden Blutzustand.
02
EMF-Exposition.
Das Blut nach einer 15-minütigen Elektrosmog-Exposition (Handytelefonat): starke Verklumpungen.
DFM belegt: Beyond Matter verbessert stark geschädigtes Blut.
Schäden durch Elektrosmog sind reversibel!
Gute Nachrichten für alle Handynutzer: Selbst stark geschädigtes Blut erholt sich dank Beyond Matter vollumfänglich.
Stark verklumptes Blut – hervorgerufen durch intensive berufsbedingte Handynutzung – normalisiert sich nach der Produkteinwirkung schon nach 30 Minuten: Bizarre Verformungen, die die Funktionsfähigkeit der roten Blutkörperchen beeinträchtigen, lösen sich durch Beyond Matter vollständig auf.
Blut wird durch Beyond Matter nicht nur stabilisiert, es wird zurückversetzt in seinen natürlichen Zustand.
Gerd Unterweger
Experte für Dunkelfeldmikroskopie
DFM belegt: Beyond Matter reduziert Stress.
So senkst du dein „Stressgrundrauschen“.
Im Dunkelfeld zeigt sich Stress anhand von „Leberinseln“, die eine Belastung der Leber zeigen.
Stress kann viele Gründe haben; unter anderem: Elektrosmog. Das Problem: Stress durch Elektrosmog entsteht pausenlos. Technische EMF (elektromagnetische Felder) erzeugen ein „Stressgrundrauschen“; eine Art „Basisbelastung“ des digitalen Zeitalters.
Die gute Nachricht: Die Leberinseln konnten durch alleinige Anwendung unserer Einlegesohlen Tom deutlich sichtbar reduziert werden.
DFM belegt: Weniger Stress und mehr Energie mit Beyond Matter.
Beyond Matter optimiert die Energieversorgung.
Testreihe 05 zeigt die Wirkkraft von EssenceX-Schungit von Beyond Matter im Vergleich zu ganz normalem Schungit.
Während normaler Schungit moderate Verbesserungen zeigt, führt EssenceX-Schungit zu einer signifikanten Reduktion von Stressmarkern und zur vollständigen Restauration der Erythrozytenfunktion und damit: der Energieversorgung.
Wichtig: Die Energieversorung des Körpers setzt die spannungsgeladene Rundform; und d.h. keine spannungsarme Verformung der Erythrozyten voraus!
Kaum zu glauben, aber wahr: Die Wiederherstellung der Energieversorung erfolgte in nur 4 Wochen (!) durch konsequente Anwendung von Basisset Essentials.
01
Ausgangszustand.
Das Blut im Ausgangszustand: Dunkle „Leberinseln“. Hinweise auf Leberbelastung (Stress).
02
Ausgangszustand.
Das Blut im Ausgangszustand: Stark verformte Erythrozyten (Pfeile). Hinweis auf Energieproblem.
04
Normaler Schungit.
Nach 30 Tagen mit normalem Schungit: Leichte Abnahme der Erythrozyten-Verformung.
05
Beyond Matter-Schutz.
Nach 30 Tagen mit Beyond Matter: Stressreduktion. Leberbelastung nicht feststellbar (Rückgang von Leberinseln).
Alle Ergebnisse im Dunkelfeld deuten darauf hin, dass Beyond Matter Symptome von Stress und Erschöpfung stark verbessert.
Gerd Unterweger
Experte für Dunkelfeldmikroskopie
DFM belegt: Beyond Matter unterstützt deine Gesundheit ganzheitlich!
Darm gesund, Mensch gesund!
Zu Beginn der Testung zeigt das Blutbild neben starken Leberbelastungen, Indikatoren einer Darmschleimhautstörung („Leaky Gut“). Beides lässt sich als typisches Zeichen von Stress deuten.
Während die Leberbelastung durch normalen Schungit leicht reduziert wird, bleibt die Darmschleimhautstörung vollständig erhalten.
Erst durch die regelmäßige Anwendung von EssenceX-Schungit in Form des Basissets Essentials kommt es zu einer signifikanten Reduktion von Stressmarkern und zur vollständigen Restauration der Darmschleimhautfunktion.
Die Ergebnisse belegen die überlegene Wirksamkeit von EssenceX-Schungit bei der Minderung von Elektrosmog-induziertem Stress und der Förderung der gastro-intestinalen Gesundheit.
01
Ausgangszustand.
Das Blut im Ausgangszustand: Dunkle „Leberinseln“. Hinweise auf Leberbelastung (Stress).
02
Ausgangszustand.
Das Blut im Ausgangszustand: Anzeichen von „Leaky Gut“ (Störung der Darmschleimhaut).
04
Normaler Schungit.
Nach 30 Tagen mit normalem Schungit: Unveränderte Störung der Darmschleimhaut.
05
Beyond Matter-Schutz.
Nach 30 Tagen mit Beyond Matter: Stressreduktion. Leberbelastung nicht feststellbar (Rückgang von Leberinseln).
Bemerkenswert ist, dass „Leaky Gut“, eine stressinduzierte Störung im Darm, durch Beyond Matter vollständig revidiert wird.
Gerd Unterweger
Experte für Dunkelfeldmikroskopie
Beyond Matter verbessert die zentrale Grundlage biologischer Gesundheit – dein Blut.
Die Dunkelfeldmikroskopie zeigt in eindrucksvoller Klarheit, wie sensibel das menschliche Blut auf elektromagnetische Belastungen reagiert: Verklumpung, Verformung der Erythrozyten, Leberinseln und Hinweise auf Darmschleimhautstress entstehen in Echtzeit – und sie beeinträchtigen unmittelbar Sauerstoffversorgung, Stoffwechsel und Energieproduktion.
Die Untersuchung belegt jedoch ebenso deutlich: Durch den Einsatz von EssenceX normalisieren sich diese Blutparameter nicht nur, sie verbessern sich zum Teil weit über das Ausgangsniveau hinaus.
Das bedeutet: Beyond Matter wirkt genau dort, wo Wohlbefinden entsteht – im Milieu und in der Funktion deiner Blutzellen:
- Freie, kugelförmige Erythrozyten transportieren Sauerstoff effizient.
- Geklärte Plasmaanteile entlasten Leber und Darm.
- Eine harmonisierte Mikrozirkulation ermöglicht Zellen, was sie am dringendsten brauchen: Energie, Nährstoffe und klare Kommunikationssignale.
Die Dunkelfeldanalyse zeigt somit nicht nur Schutz vor EMF-induziertem Stress, sondern eine tiefgehende Wiederherstellung biologischer Integrität. Anders gesagt: Beyond Matter wirkt dort, wo Gesundheit beginnt – im Blut selbst.
Beyond Matter: Strahlenschutz. Und so viel mehr!
Der Unterschied zwischen „Beyond Matter nutzen“ und „Beyond Matter nicht nutzen“ in einem Wort: Stress. Ohne unsere Produkte induziert Elektrosmog Stress im Körper. Mit unseren Produkten passiert das nicht – und mehr noch: zentrale biologische Parameter verbessern sich. Dein Plus für Erholungs- und Leistungsfähigkeit.
Keiner entkommt dem Dauer-Bombardement durch Elektrosmog.
Stress hervorgerufen durch Elektrosmog entsteht andauernd und wirkt ununterbrochen auf dich ein: durch Mobilfunk, WLAN, 5G, Bluetooth, Stromnetze, Smart-Meter und andere urbane Infrastruktur. Selbst nachts ist die Belastung konstant. Kurzum: Die Gesamtexposition ist hoch – und nimmt weiter zu.
Im Anhang findest du eine Liste von insgesamt 29 Reviews (Übersichtsarbeiten), die sich mit den biologischen Auswirkungen von Elektrosmog auf die Gesundheit beschäftigen (01).
Stress ist das, was Elektrosmog so gefährlich macht.
Elektrosmog führt zu einer Überaktivierung des Sympathikus – jenem Teil deines vegetativen Nervensystems, der Stresshormone ausschüttet und dich in erhöhte Alarm- bzw. Leistungsbereitschaft versetzt.
Das Problem: Dauerhafte Sympathikusaktivierungen haben nachteilige Folgen für praktisch jede Facette von Gesundheit: Regenerative Funktionen des Vagus (Parasympathikus) werden unterdrückt, was Erholung, Stoffwechsel, Immunsystem und mentale Stabilität schwächt. Ein biologisches Stressmuster ohne Pause.
Beyond Matter schaltet den Stress ab.
Unsere Produkte stoppen den Stress, der durch Elektrosmog pausenlos entsteht. Das autonome Nervensystem kommt zurück ins Gleichgewicht, Cortisol (Stressmarker) sinkt, die HRV verbessert sich. Der Körper kommt in eine gesündere Regulation – ohne bewusste Anstrengung, jeden Tag.
Der Nr. 1 Schutz vor Elektrosmog: Neutralisierung + Transformation = Superkompensation!
Beyond Matter bietet einen völlig neuen Ansatz im Umgang mit Elektrosmog, denn unsere Produkte neutralisieren EMF nicht nur, sie transformieren sie:
- Neutralisieren bedeutet: Unsere Produkte stoppen Elektrosmog induzierten Stress. Der Körper stellt sein ursprüngliches Gleichgewicht wieder her. Er erreicht sein Ausgangsniveau an Leistungs- und Widerstandsfähigkeit.
- Transformieren bedeutet: Elektromagnetische Wellen, die dir ohne unsere Produkte Schaden zufügen würden, verwandeln sich dank unserer Produkte in biokompatible Energie. Der Körper stabilisiert sich nicht auf seinem Ausgangsniveau, sondern wird über das ursprüngliche Niveau hinausgehend optimiert – mit anderen Worten: superkompensiert.
Kurzum: Beyond Matter macht deinen Körper dank EssenceX-Technologie widerstands- und leistungsfähiger. Dies wirkt sich positiv auf zahllose Körperfunktionen aus, wie z.B. auf mentale Fitness, Verdauung und Schlafverhalten.


Nicht sicher, was du brauchst?
Wir helfen dir gern!
Aus Erfahrung wissen wir, dass sich die meisten Fragen in einem persönlichen Gespräch schnell und einfach klären lassen. Unser ebenso bezauberndes wie kompetentes Beratungsteam freut sich auf dich!
Telefon: +49 (0) 30-75437090
E-Mail: beratung@beyondmatter.com
Mo, Di, Do, Fr: 9 bis 13 Uhr;
Mo, Mi: 14 bis 17 Uhr.
Literatur, Studien und andere wichtige Belege.
(01) Im Folgenden ein Überblick über die aktuelle wissenschaftliche Studienlage:
Balmori, A.:
Evidence for a health risk by RF on humans living around mobile phone base stations: From radiofrequency sickness to cancer.
In: Environmental Research. 2022 214(4): 113851. DOI:10.1016/j.envres.2022.113851.
Scientific Foresight Unit (STOA):
Health impact of 5G.
European Parlament:
https://www.europarl.europa.eu/RegData/etudes/STUD/2021/690012/EPRS_STU(2021)690012_EN.pdf.
Abgerufen am 7. Februar 2025.
Belpommes, D. et al.:
Thermal and non-thermal health effects of low intensity non-ionizing radiation: An international perspective.
In: Environmental Pollution. 2018 Nov; 242 (Pt A): 643-658. DOI: 10.1016/j.envpol.2018.07.019.
Bortkiewicz, A. et al:
Mobile Phone use and risk for intracranial tumors and salivary gland tumors - a meta-analysis.
In: International Journal of Occupational Medicine and Environmental Health. 2017 Feb 21; 30(1): 27-43. DOI: 10.13075/ijomeh.1896.00802.
Belyaev, I.Y.:
Non-thermal Biological Effects of Microwaves.
In: Microwave Review 2005; 11 (2): 13-29.
Umfangreichste Dokumentation der Studienlage, erstellt von einem internationalen Team von 29 führenden Experten:
The BioInitiative Report 2012:
A Rationale for Biologically-based Public Exposure Standards for Electromagnetic Fields (ELF and RF). 2012, 2014, 2020.
Di Ciaula, A.:
Towards 5G communication systems: Are there health implications?
In: International Journal of Hygiene and Environmental Health. 2018 Apr; 221(3): 367-375. DOI: 10.1016/j.ijheh.2018.01.011.
Gangi, S. & Johansson, O.:
Skin changes in "screen dermatitis" versus classical UV- and imionizing irradiation-related damage - similarities and differences.
In: Experimental Dermatology. 1997 Dec; 6(6): 283-91. DOI: 10.1111/j.1600-0625.1997.tb00174.x.
Grigoriev, Y.:
Evidence for Effects on the Immune System Supplement.
Bioinitiative Report 2012, Section 8.
https://bioinitiative.org/wp-content/uploads/pdfs/sec08_2012_Evidence_%20Effects_%20Immune_System.pdf.
Abgerufen am 1. März 2025.
Hecht, K. & Balzer, H.U.:
Biologische Wirkungen elektromagnetischer Felder im Frequenzbereich 0 – 3 GHz auf den Menschen. Studie russischer Literatur von 1960-1996 im Auftrag des Bundesministerium für Telekommunikation.
In: Umwelt-Medizin-Gesellschaft 14, 3/2001.
Hensinger, P.:
Risiko Mobilfunk – Blick in die Forschung: Gesundheitsschäden durch WLAN- und Mobilfunkstrahlung.
In: DHZ – Deutsche Heilpraktiker Zeitschrift. 2018; 8.
Hensinger, P. & Wilke, I.:
Mobilfunk: Neue Studienergebnisse bestätigen Risiken der nicht-ionisierenden
Strahlung.
In: Umwelt-Medizin-Gesellschaft. 29, 3/2016.
Khurana, V.G. et al.:
Epidemiological evidence for a health risk from mobile phone base stations.
In: International Journal of Occupational and Environmental Health. 2010 Jul-Sep; 16(3): 263-7. DOI: 10.1179/107735210799160192. 2010; 16 (3).
Kostoff, R.N. et al.:
Adverse Health Effects of 5G Mobile Networking Technology
under Real Life Conditions.
In: Toxicology Letters. 2020 May 1: 323:35-40. DOI: 10.1016/j.toxlet.2020.01.020.
Levitt, B.B. & Lai, H.:
Biological effects from exposure to electromagnetic radiation emitted by cell tower base stations and other antenna arrays.
In: Canadian Science Publishing
Environmental Reviews. 2011; 19(NA): 495-495. DOI: 10.1139/a10-903.
Mämpel, W. et al.:
Unterschätzte Gefahren durch Radioaktivität am Beispiel der Radarsoldaten.
In: Berichte des Otto Hug Strahleninstituts. Bericht 25, 2015.
Makker, K. et al.:
Cell phones: modern man's nemesis?
In: Reproductive Biomedicine Online. 2009 Jan; 18(1): 148-57. DOI: 10.1016/s1472-6483(10)60437-3.
Miller A.B. et al.: Risks to health and well-being from radio-frequency radiation emitted by cell phones and other wireless devices. Front. Public Health 7:223. 2019.
Molla-Djafari, H. et al.:
ATHEM-2. Athermal effects of electromagnetic field exposure associated with mobile communication.
In: Allgemeine Unfallversicherungsanstalt AUVA: Research Report 70, 2016.
Morgan, L.L. et al.:
Why children absorb more microwave radiation than adults: The consequences.
In: Journal of Microscopy and Ultrastructure. 2014; 2(4): 197-204. DOI: 10.1016/j.jmau.2014.06.005.
Narayanan, S.N. et al.:
Radiofrequency electromagnetic radiation-induced behavioral changes and their possible basis.
In: Environmental Science and Pollution Research. 2019 Oct; 26(30): 30693-30710.
DOI: 10.1007/s11356-019-06278-5.
Pall, M.L.:
Wi-Fi is an important threat to human health.
In: Environmental Research. 2018 Jul: 164:405-416. DOI: 10.1016/j.envres.2018.01.035.
Sage, C. & Burgio, E.:
Electromagnetic Fields, Pulsed Radiofrequency Radiation, and Epigenetics: How Wireless Technologies May Affect Childhood Development.
In: Child Development. 2018 Jan; 89(1): 129-136. DOI: 10.1111/cdev.12824.
Saliev, T. et al.:
Biological effects of non-ionizing electromagnetic fields: Two sides of a coin.
In: Progress in Biophysics and Molecular Biology. 2019 Jan: 141: 25-36. DOI: 10.1016/j.pbiomolbio.2018.07.009.
Starkey, S.J.:
Inaccurate official assessment of radiofrequency safety by the Advisory Group on Non-ionising Radiation.
In: Reviews on Environmental Health. 2016 Dec 1; 31(4): 493-503. DOI: 10.1515/reveh-2016-0060.
Simko M., Mattson M.-O.:
5G Wireless Communication and Health Effects-A Pragmatic Review Based on Available Studies Regarding 6 to 100 GHz.
In: International Journal of Environmental Research and Public Health. 2019 Sep 13; 16 (18): 3406. DOI: 10.3390/ijerph16183406.
Vornoli, A. et al.:
The Contribution of In Vivo Mammalian Studies to the Knowledge of Adverse Effects of Radiofrequency Radiation on Human Health.
In: International Journal of Environmental Research and Public Health. 2019 Sep 12; 16(18): 3379. DOI: 10.3390/ijerph16183379.
Wilke, I.:
Biological and pathological effects of 2.45 GHz radiation on cells, fertility, brain, and behavior.
In: Umwelt-Medizin-Gesellschaft 31, 1/2018.
Wu, T. et al.:
Safe for Generations to Come: Considerations of Safety for Millimeter Waves in Wireless Communications.
In: IEEE Microwave Magazine. 2015 16(2): 65-84. DOI:10.1109/MMM.2014.2377587.